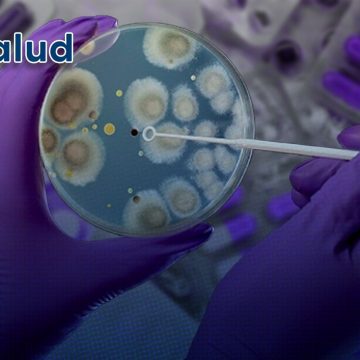

La Secretaría de Salud de México ha actualizado las cifras de muertes relacionadas con el calor extremo, informando que el número de decesos asciende a 77 con corte al 18 de septiembre de 2025.
FlashNews:
¡A octavos de final! México vence a Ecuador y mantiene el arco invicto
Embajada de Marruecos agradece a México por la hospitalidad en el Mundial 2026
Tormenta eléctrica retrasa el México vs Ecuador: ¿A qué hora se juega?
Convenciones y Parques reforzará seguridad en Puebla con 254 cámaras conectadas al C5
Guardia Nacional construye paz y seguridad para bienestar de familias poblanas
Bloquean carretera Amozoc-Oriental por presunta venta clandestina de gas LP en San Agustín Tlaxco
Subestación eléctrica asegura desarrollo industrial en San José Chiapa: Armenta Mier
Asesinan a balazos a abogado dentro de su despacho en Xicotepec
Infonavit: Cómo activar el Seguro de Daños por lluvias en Puebla
Detienen a dos hombres con arma de fuego de uso exclusivo del Ejército en Atlixco
Lluvias afectan drenaje en Diagonal Defensores; Agua de Puebla analiza el daño
¿Se cumplirá el pronóstico? Elefantes de Africam Safari eligen a México para vencer a Ecuador
Fortalece Omar Muñoz transparencia y buen gobierno en Cuautlancingo
Coparmex exhorta al Congreso de Puebla a abrir debate antes de legislar sobre derechos de menores
Gobierno de San Andrés Cholula fortalece infraestructura educativa en San Francisco Acatepec
La increíble coincidencia de fechas que marca el México vs Ecuador del Mundial 2026
Puebla será sede del Congreso Internacional MEXTESOL 2026
Anuncian la Segunda Feria del Mole en San Pedro Zacachimalpa
Guillermo del Toro se une a la Junta Directiva del Museo de la Academia de Hollywood
Etiqueta: Muertes
UNAM advierte que en 2050 la resistencia a antibióticos podría causar 10 millones de muertes al año
La resistencia a los antibióticos podría causar la muerte de 10 millones de personas al año a partir de 2050. Esta alarmante proyección fue compartida por el Dr. Samuel Ponce de León Rosales, coordinador del Programa Universitario de Investigación sobre Riesgos Epidemiológicos y Emergentes de la UNAM.
México suma 68 muertes por calor extremo
La Secretaría de Salud ha confirmado que la cifra de fallecimientos relacionados con las altas temperaturas en México ha ascendido a 68.
Altas temperaturas en México 2025: 4 muertes y 191 casos de golpe de calor
Las altas temperaturas que se han registrado en México, han provocado las primeras cuatro muertes en el país y 191 casos de golpe de calor.
Confirman muerte de 8 niños por bacteria klebsiella oxytoca
La Secretaría de Salud destacó que cuatro casos continúan en estudio y uno quedó descartado
Salud reporta 13 muertes infantiles por posible brote Klebsiella oxytoca
Cofepris realizó la inmovilización de manera preventiva y suspensión del uso y la administración de las soluciones intravenosas de nutrición parenteral
Aumenta a 61 las muertes por calor en México
Se documentaron mil 346 casos por golpe de calor
Suman 48 muertes por calor en México
Las principales causas son golpes de calor y deshidratación
Puebla es el cuarto estado con más contagios y el segundo en muertes por COVID-19
Este viernes, se ha dado a conocer que Puebla es el segundo estado a nivel nacional con el mayor número de defunciones por COVID-19 en lo que va del 2024. Esta información fue dada a conocer por la Secretaría de Salud, a través de la Dirección General de Epidemiología.
Uso de hidroxicloroquina contra COVID-19 pudo causar 17 mil muertes; revela estudio
Se basó en estimaciones de datos de pacientes hospitalizados por COVID-19 durante la primera ola
- 1
- 2